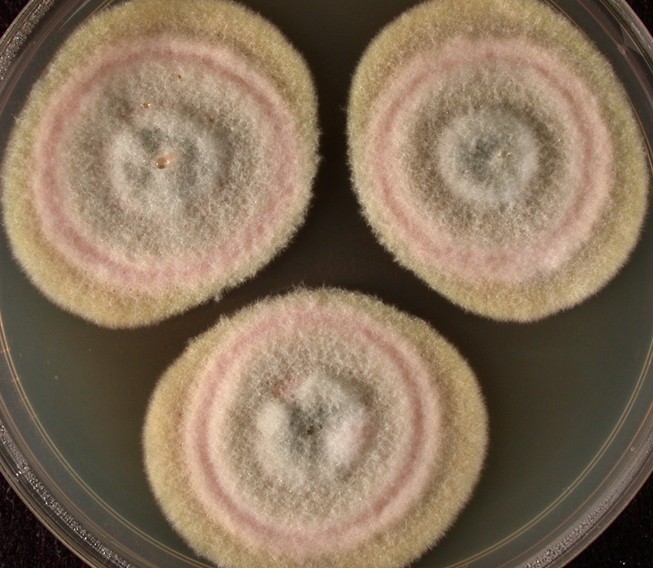

ASTM G21 Method
The ASTM G21 test method utilizes various fungal
species to determine how synthetic polymeric materials are able to hold
up to fungal growth. Although the actual synthetic
polymer component is often resistant to fungi because it does not serve
as a carbon source for growth, other components may allow for its growth
and the subsequent degradation of the material to be tested.
The method allows for various conditions of fungal
growth (moisture, humidity, temperature, salts & minerals).
The synthetic polymeric materials are exposed to the following
fungal species during testing procedures:

The standard test time for incubation is 28 days.
Each sample is observed for any visual effects and rated on a 0 to
4 scale. The samples can then be analyzed for any
effects to their physical, optical or electrical properties.
EMSL’s network of laboratories in the United States
and Canada maintain a wide range of accreditations and participate in
numerous proficiency programs. These proficiencies, accreditations and
certifications ensure that EMSL meets the highest standard of quality and
can deliver reliable and consistent results every time.
Next Page